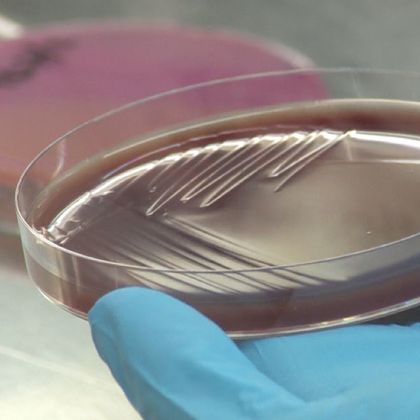

-
 Iva Tolić i Nenad Pavin (Foto: IRB) Foto: IRB
Iva Tolić i Nenad Pavin (Foto: IRB) Foto: IRB -
 Diobeno vreteno (Foto: IRB) Foto: IRB
Diobeno vreteno (Foto: IRB) Foto: IRB -
 Naslovnica (Foto: IRB) Foto: IRB
Naslovnica (Foto: IRB) Foto: IRB -
 Ekipa mladih znanstvenika koja je radila na otkriću (Foto: IRB) Foto: IRB
Ekipa mladih znanstvenika koja je radila na otkriću (Foto: IRB) Foto: IRB -
Pogledaj i ovo

NAČIN ŽIVOTA
Ugledna znanstvenica otkrila zbog čega se vratila u Hrvatsku

Bolja Hrvatska
Mladi hrvatski znanstvenici postigli velik napredak u borbi protiv bolesti koja je obilježila 21. stoljeće

Projekt Bioprospecting
Istraživanje Instituta Ruđer Bošković: Organizmima iz Jadrana do lijeka protiv raka

